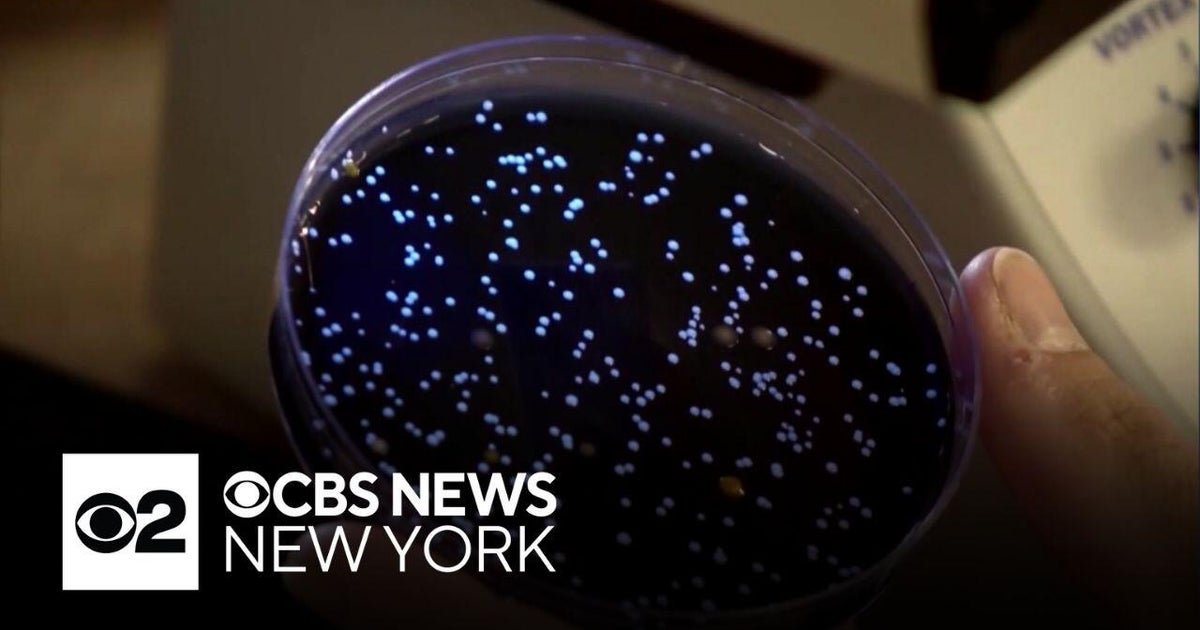

Newsletter
Subscribe our Newsletter
Join our newsletter and get the latest updates delivered straight to your inbox.
Latest News AboutHEALTH







:max_bytes(150000):strip_icc():focal(749x0:751x2)/water-towers-081525-0f21911d55424f09a776ce2f8647df62.jpg)

Cbs News•1 month ago•
990
NYC Health Commissioner Warns: Federal Budget Cuts Could Worsen Legionnaires' Disease Outbreaks
NYC Health Commissioner warns that federal budget cuts could lead to more Legionnaires' disease outbreaks. The impact on public health is a serious concern! #LegionnairesDisease #NYCHealth #PublicHealth #FederalBudget #Harlem

Syracuse.com•1 month ago•
900
Northeast States Unite Against Trump's Health Policies: A New Vaccine Coalition Emerges
Northeastern states team up to challenge Trump's health policies! A new coalition is issuing its own vaccine recommendations and coordinating public health efforts, creating a major rift with the federal government. #VaccinePolicy #PublicHealth #TrumpAdministration #NortheastCoalition #HealthPolitics

Nbc New York•1 month ago•
940
Measles Alert! NYC Health Officials Warn of Possible Exposure in Manhattan
Measles alert in NYC! Health officials warn of possible exposure in SoHo & Lower East Side. Symptoms include high fever & rash. Vaccination is key to prevention. #NYCHealth #Measles #PublicHealth #Manhattan #Vaccination

The Guardian•2 months ago•
960
Harlem Legionnaires' Disease Outbreak Declared Over After 7 Deaths
Harlem Legionnaires' disease outbreak officially over after 7 deaths and 114 cases. NYC implements new measures to prevent future outbreaks. #LegionnairesDisease #Harlem #NYCHealth #PublicHealth #Outbreak

Abc News•2 months ago•
970
Harlem Legionnaires' Outbreak: Death Toll Rises to 7, 114 Infected
Tragic update: Death toll from Legionnaires' disease outbreak in Central Harlem reaches 7, with 114 confirmed cases. Health officials warn residents to seek medical help for flu-like symptoms. #LegionnairesDisease #NYCHealth #Harlem #PublicHealth #Outbreak

Abc7 New York•2 months ago•
820
Harlem Legionnaires' Outbreak Officially Over: 114 Cases, 7 Deaths, and Proposed Reforms
Harlem Legionnaires' outbreak officially over after 114 cases and 7 deaths. NYC proposes major reforms to prevent future outbreaks. #LegionnairesDisease #Harlem #NYCHealth #PublicHealth #CoolingTowers

Fox 5 New York•2 months ago•
910
Bronx Condo Legionnaires' Outbreak Investigated: Is it Linked to Harlem?
Bronx condo residents diagnosed with Legionnaires' disease! 😱 Health officials are investigating, confirming it's a separate incident from the deadly Harlem outbreak. #LegionnairesDisease #Bronx #NYCHealth #PublicHealth #WaterSafety

Usa Today•2 months ago•
990
Harlem Legionnaires' Outbreak: 5 Dead, 100+ Sickened – What You Need to Know
Urgent: A Legionnaires' disease outbreak in Central Harlem has claimed 5 lives and sickened over 100. Health officials are investigating, urging residents to be vigilant. #LegionnairesDisease #NYCHealth #Harlem #PublicHealth #Outbreak
:max_bytes(150000):strip_icc():focal(749x0:751x2)/water-towers-081525-0f21911d55424f09a776ce2f8647df62.jpg)
People.com•2 months ago•
900
Deadly Legionnaires' Outbreak in Harlem: 4 Dead, 99 Sickened
Harlem faces a serious Legionnaires' disease outbreak, claiming 4 lives and sickening 99. Cooling towers identified as the source, while tap water remains safe. Calls for stricter regulations are mounting. #LegionnairesDisease #Harlem #NYC #PublicHealth #CoolingTowers

Cbs News•2 months ago•
910
Harlem Legionnaires' Disease Outbreak: Mayor Adams Provides Urgent Update
Urgent update on the Harlem Legionnaires' disease outbreak! Mayor Adams addresses the situation, confirming 92 cases and 3 deaths. The city is taking action to prevent further spread. #LegionnairesDisease #Harlem #NYCHealth #PublicHealth #CoolingTowers

Abc7 New York•2 months ago•
890
Harlem Legionnaires' Outbreak: 3 Dead, 70 Infected in NYC
Urgent: A Legionnaires' disease outbreak in Harlem has tragically claimed 3 lives and sickened 70 people. Health officials are investigating, urging residents with flu-like symptoms to seek immediate medical attention. #LegionnairesDisease #Harlem #NYCHealth #PublicHealth #DiseaseOutbreak

Abc News•3 months ago•
1010
Harlem Legionnaires' Disease Outbreak: 1 Dead, 22 Sick
Urgent: A Legionnaires' disease outbreak in NYC's Harlem has claimed one life and sickened 22. Health officials urge anyone with flu-like symptoms to seek immediate medical care. #LegionnairesDisease #NYCHealth #Harlem #PublicHealth #NewYorkCity

The New York Times•3 months ago•
1000
NYC's Top Hospital Under Antitrust Investigation: Price-Fixing Allegations Surface
Major NYC hospital, NewYork-Presbyterian, under federal antitrust investigation! Allegations of price-fixing and anti-competitive practices are shaking up the healthcare industry. #NYCNews #Healthcare #Antitrust #NewYorkPresbyterian #Hospital

Abc7 New York•5 months ago•
1000
Bronx Borough President Declares War on Diabetes: Is NYC Facing a Health Emergency?
Shocking numbers: 60,000 NYC adults diagnosed with diabetes yearly! The Bronx is hardest hit, prompting Borough President Vanessa Gibson to call for a health emergency declaration. #Diabetes #NYCHealth #PublicHealth #Bronx #HealthEmergency

New York Post•6 months ago•
820
NYC Hospital's Botched Circumcision Leaves Long Island Infant Fighting for Life
Horrific: A Long Island baby is fighting for his life after a botched circumcision at a NYC hospital. The parents are devastated and questioning the hospital's response. #MedicalMalpractice #NYCNews #InfantHealth #HospitalNegligence #LongIsland

Cbs News•6 months ago•
970
Miracle in NYC: One Heart Transplant Saves Three Children!
NYC miracle! One heart transplant saves THREE children! A young girl's generosity gave life to two other kids in need. #NYCmiracle #HeartTransplant #OrganDonation #MedicalMiracle #ChildrensHealth

Cbs News•6 months ago•
890
NYC Walk for Pancreatic Cancer Research: Join the Fight on May 4th!
Join the fight against pancreatic cancer! The Lustgarten Foundation's NYC Walk for Pancreatic Research is happening on May 4th, 2025 at Rockefeller Park. Let's make a difference! #PancreaticCancer #CancerResearch #NYCWalk #LustgartenFoundation #Hope

Ndtv•7 months ago•
920
NYC Doctor Fired After Controversial Hamas Support Posts
NYC doctor fired after posting pro-Hamas, anti-Israel statements on social media. The incident highlights concerns about professional conduct & patient safety. #NYCHospital #Hamas #Israel #SocialMedia #MedicalEthics

New York Post •7 months ago•
940
NYC Takes on Soaring Healthcare Costs: Anthem Blue Cross Releases Crucial Data
NYC is tackling its sky-high healthcare costs! Anthem Blue Cross will now share critical data to help rein in exorbitant hospital prices. This could save the city billions! #NYChealthcare #healthcarecosts #AnthemBlueCross #NYCPolitics #healthcaretrasparency

Cbs New York•7 months ago•
970
NYC Cats Test Positive for Bird Flu: Urgent Warning for Pet Owners
Urgent warning for NYC pet owners! Two cats have tested positive for bird flu. Health officials advise against raw pet food and outdoor roaming for cats. #BirdFlu #NYCHealth #PetSafety #AvianInfluenza #Cats

The New York Times•7 months ago•
930
NYC Pet Cats Die from Bird Flu: What You Need to Know
Two pet cats in NYC have died from the H5N1 bird flu. While the risk to humans is considered low, health officials are closely monitoring the situation. #BirdFlu #NYCHealth #H5N1 #PetHealth #PublicHealth

The New York Times•7 months ago•
950
Measles Outbreak in NYC & NJ: What You Need to Know
Measles cases are on the rise in NYC & NJ! Experts emphasize the importance of vaccination to protect yourself and your community. #MeaslesOutbreak #NYCHealth #NJHealth #Vaccination #PublicHealth

The New York Times•7 months ago•
930
Measles Outbreak in Texas Spreads Fears to NYC: Is Your Vaccination Up-to-Date?
Urgent! Measles cases surge in Texas, sparking a NYC health advisory. Is your vaccination up-to-date? #Measles #NYCHealth #Vaccination #PublicHealth #TexasOutbreak

Cbs New York•7 months ago•
920
NYC Measles Cases Spark Health Alert: What Parents Need to Know
NYC measles cases spark health concerns! Two cases confirmed, highlighting the importance of MMR vaccination. Low vaccination rates put vulnerable populations at risk. #NYCHealth #Measles #MMRVaccine #PublicHealth #Vaccination

Rolling Stone•7 months ago•
990
Measles Outbreak Spreads to NYC: 2 Cases Reported Amidst Texas Tragedy
Measles outbreak spreading! NYC and NJ report new cases linked to a deadly Texas outbreak. One child has tragically died. Vaccination remains crucial. #MeaslesOutbreak #NYCHealth #NJHealth #Vaccination #PublicHealth

Usa Today•7 months ago•
860
NYC Reports Second Measles Case Amidst Texas Outbreak: What You Need to Know
NYC sees a second measles case as a major outbreak rages in Texas, claiming one life. The highly contagious virus underscores the importance of vaccination. #MeaslesOutbreak #NYCHealth #PublicHealth #Vaccination #MMRVaccine

New York Post •8 months ago•
980
NYC Hazmat Scare: Ebola Ruled Out, Norovirus Suspected
NYC on high alert! A hazmat response at a Manhattan CityMD initially raised concerns about Ebola, but thankfully, it's likely just norovirus. The scare highlights the importance of rapid disease investigation and public health response. #NYChealth #Ebola #Norovirus #NYCemergency #PublicHealth

Nbc News•8 months ago•
860
NYC Doctor Defies Trump's Transgender Care Ban: 'Their Lives Depend On It'
NYC doctor defies Trump's ban on transgender care for minors, saying it's life-sustaining. The move sparks fear among patients & legal challenges. #TransgenderRights #GenderAffirmingCare #NYPolitics #Healthcare #LGBTQ

Cbs News•8 months ago•
800
NYC Poultry Markets Temporarily Closed Amid Bird Flu Outbreak
NYC takes swift action! Poultry markets temporarily closed due to a bird flu outbreak. Governor Hochul's proactive measures prioritize public health. #BirdFlu #NYC #PublicHealth #Poultry #GovHochul

Fox 5 New York•8 months ago•
840
NYC Flu Cases Soar to Highest Levels Since 2020!
NYC flu cases hit highest levels since 2020! Over 23,000 positive cases reported last week. Hospitalizations surge, outbreaks rise in long-term care facilities. Experts recommend getting a flu shot and practicing good hygiene. #NYCflu #fluseason #publichealth #NewYorkCity #health